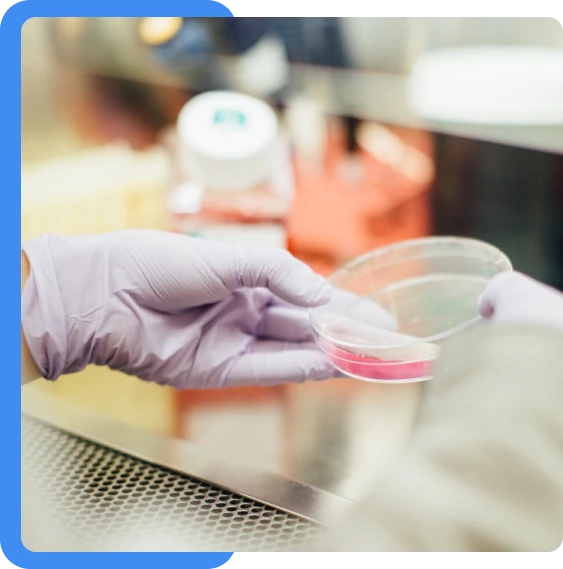

PRODUCTS
Advanced Medical Equipment Designed for Trust, Safety and Performance
Patient Monitors

Ventilation Systems

Neurology

Cardiology

Resuscitation

Accessories & Consumable

Syringe Pumps

Infusion Pumps

Fluid Warmers

Patient Warmers

CSSD Solutions

OT Lights

OT Tables

CPR Simulators

Patient Simulators

Skill Training Simulators

PRODUCTS
Advanced Medical Equipment Designed for Trust, Safety and Performance
Patient Monitors

Ventilation Systems

Neurology

Cardiology

Resuscitation

Accessories & Consumable

Syringe Pumps

Infusion Pumps

Fluid Warmers

Patient Warmers

Autoclave Sterilizer

OT Lights

OT Tables

CPR Simulators

Patient Simulators

Skill Training Simulators

WHY CHOOSE US
Trusted by Hospitals. Driven by Quality. Committed to Care.
Reliable Supply Chain
We ensure timely and efficient delivery of medical equipment so hospitals never face delays in critical care.
Quality You Can Depend On
Every product we provide meets strict quality standards for performance, safety and durability.
Customer-First Approach
We focus on long-term relationships through transparent communication, responsive support and consistent service.
Years in Business
Happy Customers
Customer Satisfaction


ABOUT US
Your Trusted Partner in Building Stronger Healthcare Systems
MM Medical Systems Pvt. Ltd. is dedicated to strengthening healthcare infrastructure across South India. We supply advanced medical equipment with a strong focus on quality, reliability and service excellence. Our goal is to support hospitals with solutions they can truly depend on.
Serving hospitals across South India with trusted medical equipment
Committed to timely delivery and operational efficiency
Focused on customer satisfaction and long-term partnerships
Dedicated to employee growth and a positive work environment
SOLUTION
Smart Medical Solutions for Modern Healthcare Needs
We provide advanced medical solutions designed to meet the evolving needs of hospitals. Our approach ensures better efficiency, improved patient care and seamless integration. From supply to support, we simplify healthcare operations.

ICU Solutions

Emergency & Trauma Care

Operation Theatre Solutions

Neonatal Care Solutions

Training & Simulation Solutions
Services & Support
Reliable Service and Support That Goes Beyond Expectations
Our services go beyond equipment supply. We offer responsive support, guidance and reliable assistance at every step. Your success and satisfaction remain our top priority.



